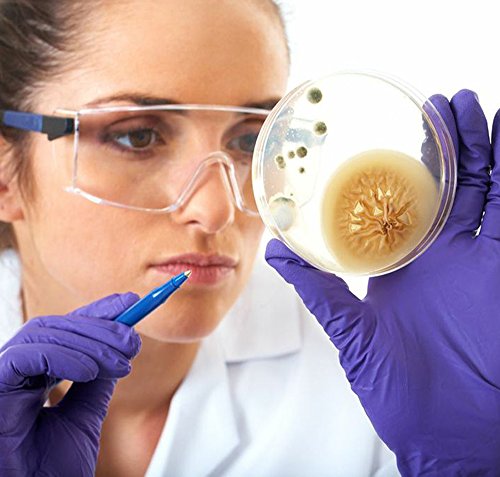

SKINTX CB2-50005-S-BX Nitrile Medical Grade Examination Glove, 3 mil - 4 mil, Powder-Free, Latex-Free, Finger Textured, 200/bx Eco-Friendly Packaging, Cool Blue (Pack of 200)[Product Information]- Enter your model numberto make sure this fits.
- Manufactured without Natural Rubber Latex, helping protect you from Type I (Latex) Allergies
- Great for handling small instruments, where fit and feel is key - Perfect for dental, medical or laboratory applications
- Smart, Economical Eco-Friendly packaged at 200 gloves per box, 2000 gloves per case provides more gloves with less effort, space and waste while easily fitting in all dispensers
- Finger Textured ensuring extra protection for wet or dry grip and against slippage
- Powder-Free gloves leave no residue, reducing the risk of contamination compared to a powdered glove, making them suitable for use in electronic components, forensic and laboratory applications